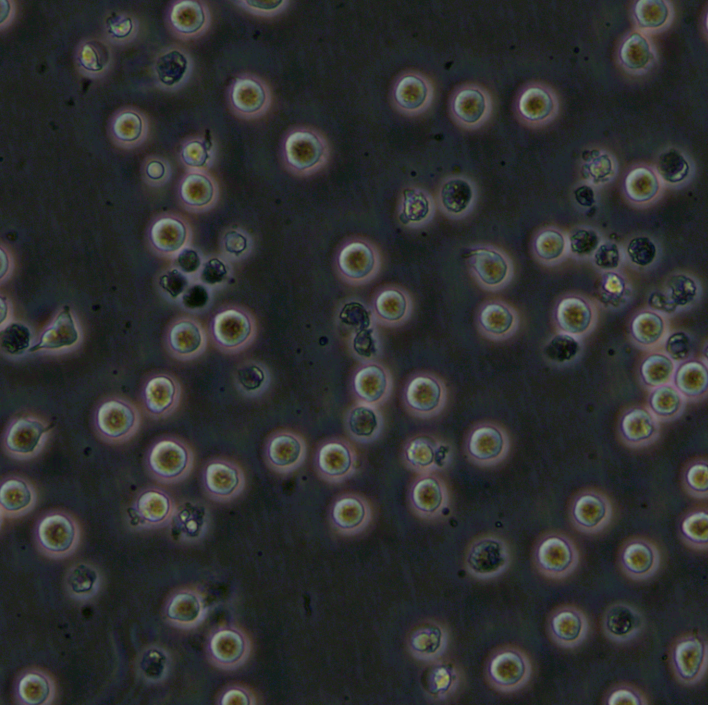
COC1细胞;人卵巢癌细胞

- 商品简介
- 购买记录
- 顾客评价()
基本信息
- 产品名称: COC1细胞;人卵巢癌细胞
- 产品编号: CL0073
- 细胞数量: 1*10^6
- 组织来源: 卵巢
- 细胞种属: 人源
- 生长特性: 悬浮
- 培养基: RPMI-1640培养基
- 形态特征: 圆形或椭圆形
- 培养条件: 胎牛血清至最终浓度为10%。环境:空气,95%;二氧化碳(CO2),5%;温度,37℃
- 细胞冻存: 液氮冻存(冻存液基础培养基+20%FBS+10%DMSO)
- 细胞运输: 干冰运输(2ml冻存管)或活细胞运输(T25瓶)
注意事项
冻存细胞接收后的处理:
1.干冰运输,收到细胞后立即转入-80℃冰箱短暂中转或直接复苏;2.收到细胞后,若发现干冰已经完全挥发、冻存管瓶盖破裂脱落,请立即拍照后与我们联系。
复苏细胞接收后的处理:
1.收到细胞后,请首先检查培养瓶是否破损或漏液,培养液是否混浊,如有漏液及培养液混浊情况请立即拍照把图片发给我们。2.75%酒精消毒瓶身后放培养箱中静置4-6h后,在显微镜下确认细胞状态并拍照100倍和200倍的照片,若有贴壁细胞脱落,可收集上清离心,将沉淀用新的培养基接种至新的培养瓶或培养皿中。
3.建议收到当天不要消化处理,如果细胞长满90%,可选择传代处理。
4.如您收到细胞3天内没有反馈相关问题,出现的细胞问题将不提供免费重发服务。
细胞培养方法:
1、细胞传代:细胞密度达到80-90%时即可传代①弃去培养上清,用PBS或生理盐水清洗1-2次;
②加入2ml0.25%胰酶(T25瓶),使胰酶覆盖整个瓶或皿,盖好放入培养箱消化;
③1-2min后,显微镜下观察细胞,若大部分细胞回缩且有少量细胞脱落,轻轻吹打下确认消化情况后加入完全培养基终止消化;若细胞还是贴壁,放回培养箱继续消化至可以轻轻吹打下为止;
④将细胞悬液1000RPM左右条件下离心4min,弃上清;
⑤用新鲜培养基重悬后加入培养瓶或皿中,T25培养瓶加6-8ml培养基;
⑥悬浮细胞直接离心收集,细胞沉淀重悬后分到新培养瓶中。
2、细胞复苏:
①将冻存管在37℃温水中快速摇晃融化,时间1min左右,加入4-5ml培养基混匀。
②在1000RPM左右条件下离心4min,弃上清,加1-2ml培养基吹匀,将细胞悬液加入培养瓶中,补加适量培养基。
3、细胞冻存:待细胞生长状态良好时进行细胞冻存保种
①弃去培养上清,用PBS或生理盐水清洗1-2次,加入1mL 0.25%胰蛋白酶(T25瓶)
②1-2min后,显微镜下观察细胞,大部分细胞回缩且有少量细胞脱落,轻轻吹打下确认消化情况后加入完全培养基终止消化;
③将细胞悬液1000RPM左右条件下离心4min,弃上清,加1ml冻存液重悬细胞;
④将冻存管放入程序降温盒,放入-80℃冰箱,4小时后将冻存管转入液氮罐储存。
▍购买记录(近期成交数量0)
还没有人购买过此商品
▍用户评论(共0条评论)
- 暂时还没有任何用户评论
▍最近浏览过的商品

© 2005-2026 U商城-普拉特泽生物 版权所有,并保留所有权利。ICP备案证书号:湘ICP备17023651号

在线客服
在线客服